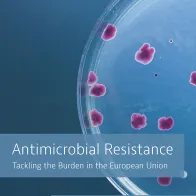
Cover of the briefing note: Antimicrobial Resistance - Tackling the Burden in the European Union

SAVE LIVES: Clean Your Hands – ECDC supports World Hand Hygiene Day 2019

Healthcare-associated infections, including those caused by bacteria resistant to antibiotics, are a growing public health problem in Europe. In fact, 75% of the health burden of infections with bacteria resistant to antibiotics in Europe is due to healthcare-associated infections. However, a large percentage of these are preventable by improving hand hygiene practices as hand hygiene is the ‘single most important measure’ to prevent transmission of bacteria in hospitals and other healthcare settings, according to the World Health Organization.
With the slogan “Clean care for all – it's in your hands”, the WHO calls on everyone to be inspired by the global movement to achieve universal health coverage. Infection prevention and control, including hand hygiene, is critical to achieve universal health coverage as it is a simple, practical and evidence-based approach with demonstrated impact on quality of care and patient safety across all levels of the health system. ECDC supports this campaign and highlights the importance of infection prevention and control measures as one of the main strategies to tackle the growing threat posed by antibiotic resistance.
Get informed
Last year, ECDC published the results of two point prevalence surveys of healthcare-associated infections and antibiotic use in hospitals and in long-term care facilities in the EU/EEA. The findings show that 8.9 million Healthcare-associated infections occur each year in both hospitals and long-term care facilities. Prevalence of antibiotic use as well as infection prevention and control practices vary greatly between countries throughout Europe and there is still room for improvement in many countries. Overuse use of antibiotics and varying infection prevention and control practices result in increased emergence and spread of multidrug-resistant bacteria.
Video: 7 things you don’t want to share – keep your hands clean!
Hand hygiene in healthcare has saved millions of lives in the last years worldwide. Nevertheless, many people forget to clean their hands and keep spreading bacteria. There are things you just don’t want to share, like the pin code for your credit card, your location when you’re away from home, your toothbrush or used medical gloves. Why share diseases when you can easily keep your hands clean?
Other resources
The OECD, in collaboration with ECDC, has produced a briefing note on antimicrobial resistance (AMR) in the European Union and the European Economic Area. It presents key estimates of the health and economic impact of AMR and effective strategies to address this major public health threat.

The directory lists strategies, action plans, guidance documents, training courses and research projects on the prevention and control of antimicrobial resistance and healthcare-associated infections available online. These documents were published by ECDC, EU/EEA and other countries, international and national agencies, professional societies to support healthcare professionals, hospital administrators and public health professionals.
Share this page





